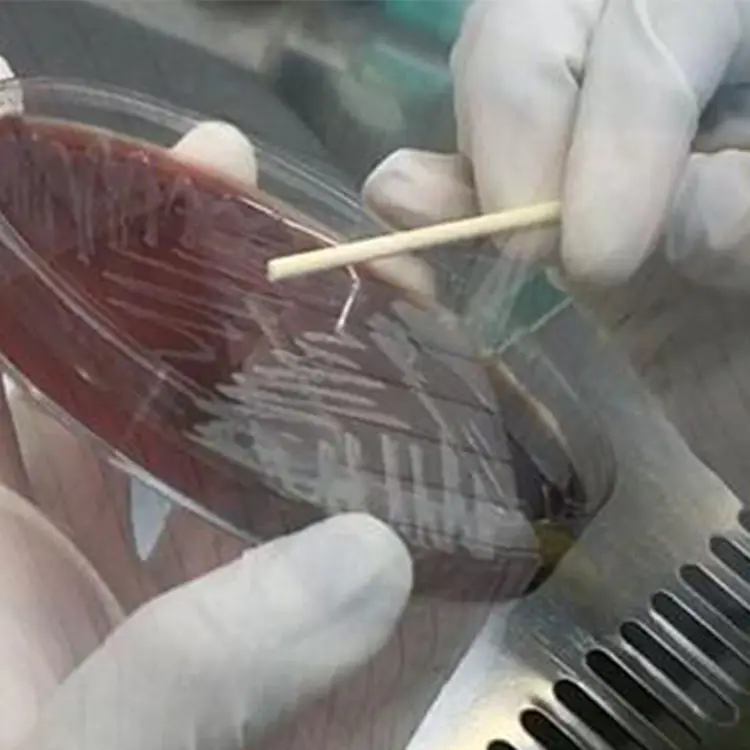
Desktop High-Precision Mass Spectrometer System Portable Microbial Mass Spectrometer

Desktop High Precision Mass Spectrometer System Portable Microbial Mass Spectrometer
- Category: >>>
- Supplier: Zhuhai Meihua Medical Technology Co. Ltd.
Share on (1601017059372):
Product Overview
Description
Products Description

item | value |
Type | Blood & Gas Analysis System |
Brand Name | Meihua |
Model Number | MD100 |
Place of Origin | China |
Guangdong | |
Instrument classification | Class II |
Warranty | 2 years |
After-sale Service | Online technical support |
Product name | mass spectrometer |
Product show

Meihua MALDI-TOF Microbial mass spectrometry System Highlights:
1) Rapid, Accurate, Seconds for a reliable result
2) High throughput of single target plate, 96 target simultaneously
3) High Stability, Automated vacuum protection, Patented cabin entry,
4) Intelligent adjustment of laser power
5) Automated and manual modes for sample acquisition, QC & identification
6) Support local enrichment of database
Accurate
Comprehensive database of more than 2000 species and 6000 strains to support identification of a vast range of samples.
Automated quality control in multiple position to decrease the impact of dis-homogeneity of target plate
Advanced algorithm for filtration of invalid data and spectrum
Stable
Automated vacuum protection
Patent cabin entry design to avoid plate jam
Pump installed inside the instrument to guarantee its performance and decrease noise
Cost-Effective
Low reagents consumption, minimum sample volume and high throughput
Less preparation works for sample processing to save time and labor cost
Recycling target plates
Expert Software
Simple clicks to complete automatically registration, QC, sample acquisition, identification and final report
Import and export of data for higher working efficiency
Batch and real-time data processing and analysis
1) Rapid, Accurate, Seconds for a reliable result
2) High throughput of single target plate, 96 target simultaneously
3) High Stability, Automated vacuum protection, Patented cabin entry,
4) Intelligent adjustment of laser power
5) Automated and manual modes for sample acquisition, QC & identification
6) Support local enrichment of database
Accurate
Comprehensive database of more than 2000 species and 6000 strains to support identification of a vast range of samples.
Automated quality control in multiple position to decrease the impact of dis-homogeneity of target plate
Advanced algorithm for filtration of invalid data and spectrum
Stable
Automated vacuum protection
Patent cabin entry design to avoid plate jam
Pump installed inside the instrument to guarantee its performance and decrease noise
Cost-Effective
Low reagents consumption, minimum sample volume and high throughput
Less preparation works for sample processing to save time and labor cost
Recycling target plates
Expert Software
Simple clicks to complete automatically registration, QC, sample acquisition, identification and final report
Import and export of data for higher working efficiency
Batch and real-time data processing and analysis
Related Products

Company Profile



Transport Logistics


FAQ

Q: How to purchase your products ?
A: Please inform us your detailed requirement or demand, we will offer some recommendation. After your confirmation, we will issue a formal proforma invoice (PI) for your final confirmation and payment. You can purchase from us directly or via Alibaba Trade Assurance Order.
Q: What's the warranty for the products ?
A: The standard warranty is one year from the date of arrival. In addition, we will still provide good after-sales service after warranty period.
Q: What kind of after-sales service include?
A: Online Technical Support, other remote technical support; Spare part support, Training, Field Service if requested
Q: Can we visit your factory ?
A: Of course, welcome to visit our factory if you come to China.
Q: What's the production date after we confirm the order ?
A: This depends on the quantity and specific requirement. Normally, for the mass production, we need about 35-40 days to finish the production. For some regular reagents, we can provide within 7 days after the confirmation.
Q: Is OEM or ODM service available
A: Available upon request.
A: Please inform us your detailed requirement or demand, we will offer some recommendation. After your confirmation, we will issue a formal proforma invoice (PI) for your final confirmation and payment. You can purchase from us directly or via Alibaba Trade Assurance Order.
Q: What's the warranty for the products ?
A: The standard warranty is one year from the date of arrival. In addition, we will still provide good after-sales service after warranty period.
Q: What kind of after-sales service include?
A: Online Technical Support, other remote technical support; Spare part support, Training, Field Service if requested
Q: Can we visit your factory ?
A: Of course, welcome to visit our factory if you come to China.
Q: What's the production date after we confirm the order ?
A: This depends on the quantity and specific requirement. Normally, for the mass production, we need about 35-40 days to finish the production. For some regular reagents, we can provide within 7 days after the confirmation.
Q: Is OEM or ODM service available
A: Available upon request.
We Recommend
New Arrivals
New products from manufacturers at wholesale prices